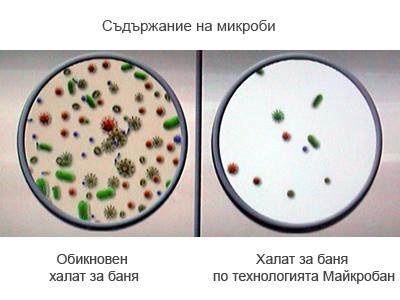
Съдържание на микроби

Спално бельо, шалтета, хавлии, халати за баня, дамаски | Онлайн магазин Див Дом
начало » Плесени и микроби – има начин да се предпазим
Микроорганизмите са живи клетки, които са твърде малки, за да се видят с невъоръжено око и трябва да се гледат през микроскоп. С невъоръжено око може да се види наличието им, едва когато те са се умножили до стотици хиляди. Тези микроорганизми включват в себе си бактерии, гъбички, мухъл и др.
Не можем да заобиколим наличието на микроорганизми в действителност. Много от бактериите, с които се сблъскваме са от полза за околната среда и дори за човешкото тяло. Въпреки това някои лоши бактерии имат неблагоприятно влияние върху продуктите от ежедневието ни – причиняват петна, лоши миризми и предизвикват дори алергии.
Оказва се, че влажната баня е идеална среда за развитието на микроорганизми. Особено подходящо убежище за тези микроскопични създания са хавлиените халати и кърпите за лице и ръце. Лошата новина е, че при подходящи условия техният брой може да се удвоява на всеки 15-20 минути. Достигайки колосални бройки тези малки създания предизвикват неприятни миризми и неприятни петна.
За щастие има и добра новина. В последните години беше разработена технологията Microban® (Майкробан®). В процеса на производство към основния материал се добавят органични и неорганични вещества, които придават антибактериалните свойства на продукта. Ефективността на Майкробан се потвърждава от множество лабораторни тестове в Европа и Америка.
Резултатите от изследваните изделия с Майкробан технология, показват че технологията наистина спира размножаването на множество лоши бактерии, освен това с течение на времето, свойствата на Майкробан не изчезват.
Тестове показват също, че значително намалява процентът на раковите заболявания при хора, които използват продукти с антибактериална защита Майкробан®
У нас също започнаха да се продават продукти с антибактериална защита. Една от марките халати и хавлии, която ползват тази технология е Hamam. Произвеждат от изключително качествени естествени материали, като в процеса на производство вграждат технологията Microban®.
Тези продукти са създадени, за да допълнят върховното изживяване от докосването на тялото и водата. Идеални за душ, парна баня или сауна, те добавят своята енергия към стремежа Ви за здравословен живот, красота и грижа за себе си. Hamam предлага изключителна колекция от хавлии, халати, парео и други.


Друга марка, която предлага антибактериална защита е Еке. Цените са малко по-ниски, но качеството е конкурентно. Моделите са по-традиционни, но също не отстъпват по красота.





























